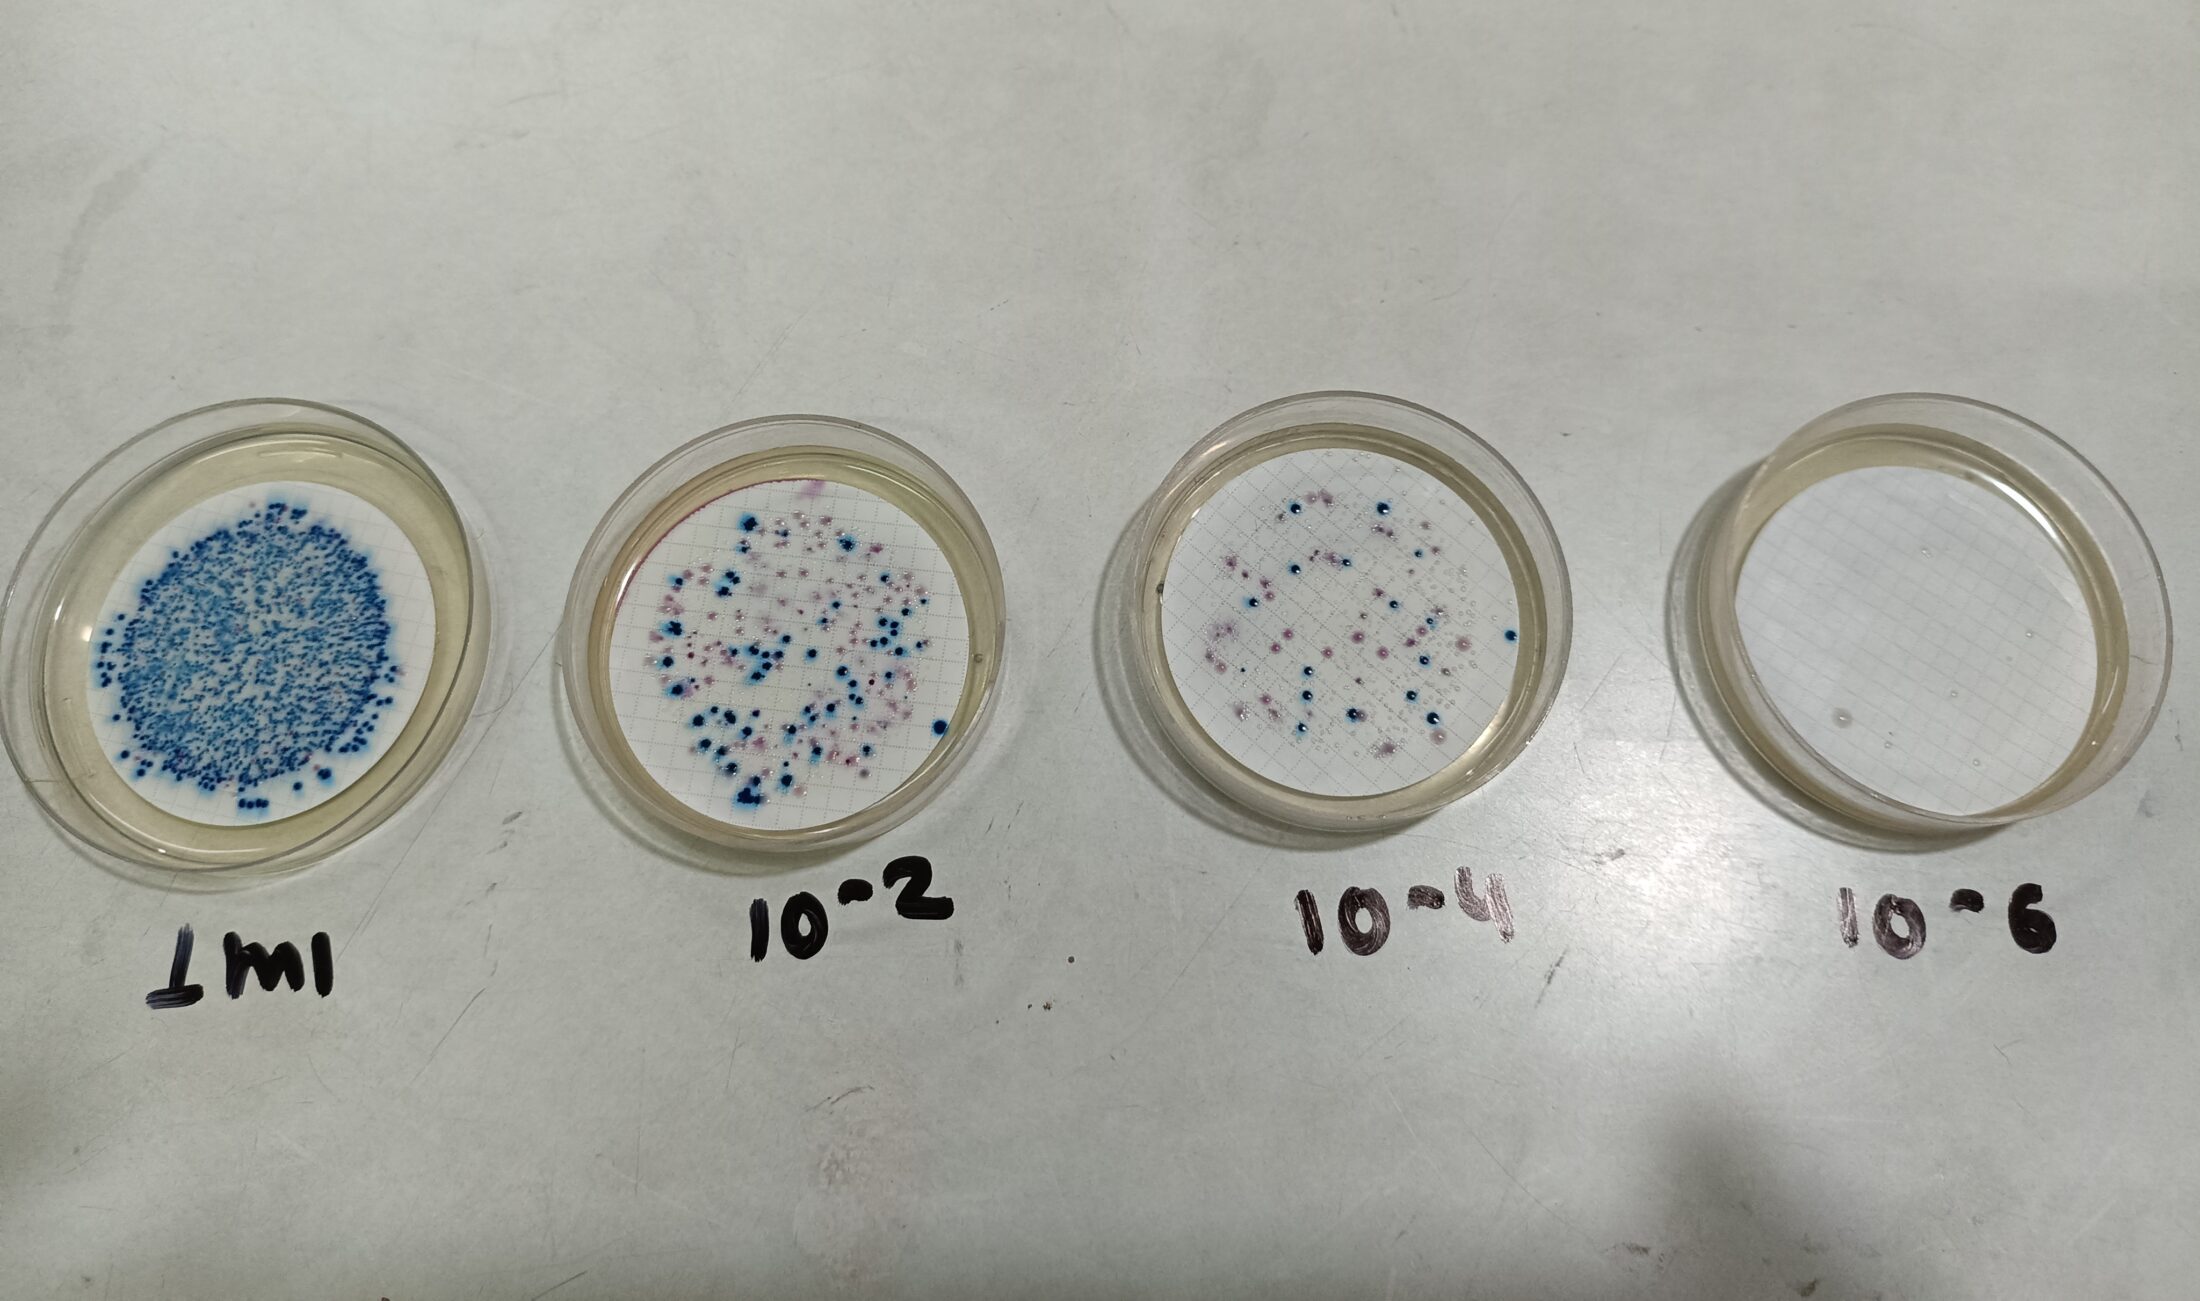

ENPHO | Environment and Public Health Organisation

Contact
Pramina Nakarmi
pramina.nakarmi@enpho.org
+977 1-5244641
ENPHO | Environment and Public Health Organisation
44600 Kathmandu
Nepal
enpho.org
About
Environment and Public Health Organization
(ENPHO) is an NGO established in 1990 with a
vision of creating eco-societies by providing
quality services on water, sanitation and
hygiene (WASH), environment and public
health. Since its establishment, ENPHO
laboratory, as a division under ENPHO, has
been providing analytical services in water,
wastewater, air, food, soil quality, and recently
in faecal sludge analysis. ENPHO laboratory is
equipped with trained professionals and
advanced equipment. ENPHO laboratory is
accredited by Nepal Bureau of Standards and
Meteorology (NBSM), Government of Nepal. It has
been providing a platform for research and
monitoring activities on faecal sludge through
its characterization in terms of nutrients, solids,
organic matter, heavy metals and
microbiological parameters including
helminths eggs.For more details about ENPHO
please visit http://enpho.org/research-anddevelopment/.